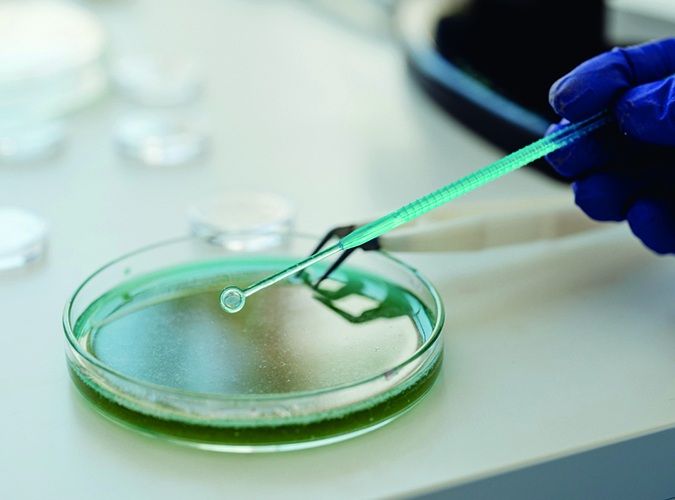

Marco Panetta, Chiara Mantovani – SAFIC-ALCAN ITALIA
Miguel Angel Sanchez, Marta Sacristaan Benito – TOLSA
CIT (clorometil-isotiazolinone), MIT (metil-isotiazolinone) e BIT (benzisotiazolinone) appartengono alla famiglia degli isotiazolinoni, una classe di biocidi largamente utilizzata come conservante in numerosi prodotti a base acqua, tra cui vernici, colle, detergenti e cosmetici. Il loro impiego è motivato dall’elevata efficacia contro batteri, muffe e alghe, anche a basse concentrazioni. Tuttavia, l’uso di queste sostanze solleva crescenti preoccupazioni a livello sanitario e normativo, a causa della loro tossicità e allergenicità.
Negli ultimi anni, MIT e CIT sono stati riconosciuti come forti sensibilizzanti cutanei, responsabili di un incremento significativo dei casi di dermatite allergica da contatto, soprattutto in ambito professionale e domestico. L’esposizione può avvenire sia durante l’applicazione della vernice, sia attraverso il semplice contatto con superfici trattate. La combinazione CIT/MIT, in particolare, è tra le più reattive e attualmente soggetta a restrizioni severe imposte dall’UE.
Il BIT, sebbene ritenuto meno aggressivo dal punto di vista dermatologico rispetto a MIT e CIT, non è privo di rischi: anche questo composto può causare irritazioni cutanee, oculari e respiratorie, soprattutto in ambienti scarsamente ventilati o in caso di esposizioni prolungate.
A livello normativo, l’uso di questi conservanti è sempre più regolamentato, con limiti di concentrazione precisi e obblighi di etichettatura per segnalare il rischio di allergie. Nonostante ciò, la loro presenza resta comune nei prodotti vernicianti all’acqua, rendendo necessario un uso consapevole e l’adozione di adeguate misure di protezione, soprattutto per operatori professionali e soggetti sensibilizzati.
Quindi, se da un lato CIT, MIT e BIT garantiscono la stabilità microbiologica delle vernici all’acqua, dall’altro rappresentano un rischio concreto per la salute umana e devono essere gestiti con attenzione, alla luce delle evidenze tossicologiche e delle normative vigenti.

Tutto ciò ha stimolato la ricerca di alternative più sicure, ma le alternative analogamente efficaci rimangono ancora limitate.
La business unit Functional Additives di TOLSA, che già da anni propone sui mercati europei ed internazionali la propria gamma di additivi antimicrobici denominati Adins® Protection, nati dall’esperienza di TOLSA nell’estrazione e nella lavorazione dei silicati, propone ora la propria alternativa inorganica ai preservanti in latta organici.
Adins® Protection N4 è un additivo antimicrobico innovativo: agisce come un efficace conservante in latta, prevenendo la degradazione microbica durante lo stoccaggio e garantendo la qualità del prodotto prima e dopo l’applicazione. La tecnologia di incapsulamento Adins permette di incorporare diverse sostanze attive su silicato, ottenendo una distribuzione uniforme ed un’elevata superficie attiva, che si traducono in un altissimo potere antimicrobico già a bassissimi dosaggi.

Il prodotto si presenta in forma di polvere bianca, è chimicamente inerte all’interno dei formulati, non genera variazioni di colore, è utilizzabile in prodotti trasparenti e non modifica la brillantezza superficiale. Offre infine una leggera azione addensante ed una piena azione di conservazione in latta ed antibatterica su film secco per i prodotti all’acqua, che non necessiteranno più di conservanti organici.
Benefici di Adins® Protection N4
Non ultimo, TOLSA offre gratuitamente alle aziende interessate la possibilità di valutare l’efficacia di Adins® Protection N4 nei propri formulati, secondo la norma ASTM D2574-16 (resistenza delle vernici in emulsione acquosa contro l’attacco di microorganismi in latta).
Di seguito l’intera gamma dei prodotti antibatterici dell’azienda disponibili per l’Europa, basati su differenti sostanze attive:
TOLSA è una multinazionale spagnola che impiega 800 persone su 14 miniere e 15 siti produttivi. La società ha una chiara vocazione internazionale ed è leader nell’estrazione, trattamento e commercializzazione di minerali. Safic-Alcan è il partner selezionato dall’azienda spagnola per lo sviluppo del mercato di questa serie di additivi in Italia.
L’azienda è un distributore francese di specialità chimiche con sede a Parigi. L’azienda sviluppa e fornisce un’ampia gamma di polimeri, materiali e additivi per gomma, coating, adesivi, industrie termoplastiche, poliuretani, lubrificanti, detergenza, cosmetica, farmaceutica e nutraceutica. Con una rete di 42 locations strategicamente dislocate in Europa, Medio Oriente, Nord America, Asia e Sud Africa, l’azienda rappresenta produttori all’avanguardia in tutto il mondo. I suoi tecnici di vendita altamente specializzati consentono a Safic-Alcan di fornire competenze tecniche dedicate e soluzioni ad alte prestazioni, creando così partnership a lungo termine con la maggior parte di committenti e clienti. Safic-Alcan impiega 800 persone nel mondo e ha generato un fatturato di 910 milioni di Euro nel 2024.
